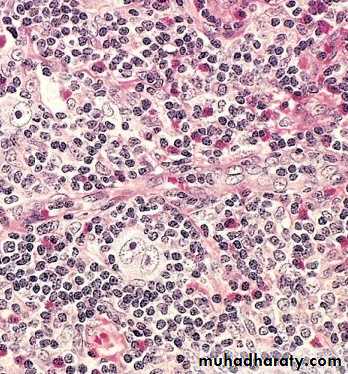

د. منى امراض 7+LEC:6
عدد الاوراق( 9 ) م/3/موصل 11/2/2018
Lympho Reticular System
The lymphoreticular system is involved in the defence of
the body against microorganisms and foreign substances –
i.e. the immune response.
Consists of :
Thymus ,
Spleen ,
Lymph nodes ,
Mucosa Associated Lymphoid Tissue (MALT) in Gut and Upper respiratory tract ,
Bone Marrow.
Lymph node
Under normal conditions lymph nodes are small bean shaped structures
major peripheral locations (e.g. cervical, axillary or inguinal) are seldom palpable.
Their primary function is to entrap foreign agents or
unwanted materials & an immune response .
Pathology of lymphoretiocular system:
Anatomy and histology:
Lymph nodes are discrete structures surrounded by fibrous capsule which is perforated by multiple afferent lymphatics that empty into the subcapsular sinus.
Pathology of lymphoretiocular system:
Anatomy and histology:
Lymph nodes are discrete structures surrounded by fibrous capsule which is perforated by multiple afferent lymphatics that empty into the subcapsular sinus.
The lymphoid tissue in a lymph node is distributed into two main areas; cortex and medulla.
The cortex lies subjacent to the subcapsular sinus and the lymphocytes form spherical aggregates called primary follicles, the center of this follicle contain immunologically inactive B cells. The areas in between the primary follicles is called the parafollicular regions filled with numerious T- lymphocytes
The medulla lies deep to the cortex and contains plasma cells and few lymphocytes with medullary sinosoid.
Lymphadenitis:This is the inflammation of the lymph nodes. This can be classified into the following types :
1. Acute Lymphadenitis:
· Specific
· Non-specific
2. Chronic Lymphadenitis:
· Specific
· Non-Specific
Acute Lymphadenitis (Specific). This may be :
Localized e.g. Regional Lymph ,Node in appendicitis and tonsillitis, extremities infection.
Generalized e.g In Viraemia, Bacteraemia (More
common in children)
Acute Lymphadenitis (Non-Specific)
Acute lymphadenitis may be due to the Common Organism like Staph, which leads to localized abscess. Streptococci leads to cellulites.
Chronic Lymphadenitis (Non-specific) classified into:
1.B-Cell Hyperplasia (Follicular hyperplasia)
Causes of B-cell hyperplasia:
Secondary Syphilis
Toxoplasmosis
AIDS.
Microscopic appearance of B-cell hyperplasia:
Germinal centers are enlarged.
2.Paracortical Hyperplasia (T-cell Hyperplasia)
There is predominantly hyperplasia of T cells. Expansion of T-cell regions with effacement of follicles3Sinus Pattern of Hyperplasia
Sinus histiocytosis – a proliferation of histiocytes in the sinuses – is a common reaction most often seen in nodes draining malignant tumors as Ca.BreastNote:In secondary metastasis in the LN ,there is loss of architecture with present of malignant cells or tissues related to malignant organ
Specific Chronic Lymphadenitis
May be seen in –
Tuberculosis.
Brucellosis.
Sarcoidosis
Histoplasmosis
Granulomatous Pattern
These are lymphadenopathies that are characterized
by the presence of granulomas or localized aggregates
of histiocytes as the most prominent feature.
T.B , toxoplasmosis, syphilis, sarcoidosis, fungal infection
Sarcoidosis
Diagnosis is always one of exclusion;
Lung (90%), LN’s, eyes, skin most commonly affected
Non-caseating granulomatous inflammation in nodes/skin,
with scattered Langhans’ giant cells
Necrosis is absent
Schaumann bodies and calcium oxalate crystals in cytoplasm of giant cells; none are specific
Kveim test: 60-85%
Sarcoidosis: lymph node
Suppurative granulomas :
It is characterized by the presence of neutrophilis within the necrosis of granuloma, examples:Cat scratch disease; young patient with GLA, fever, exposed to pet animal.
Lymphogranuloma venerium : chlamydial infection , sexually transmitted disease mainly in adult males.
Yersienia pseudotubrculosis; in mesenteric nodes in young adults .Simulates appendicitis.
Hodgkin lymphoma
Is a primary malignant tumor of lymphoreticular system25% of all lymphomas.
It is defined pathologically by the presence of large tumor cells called Reed-Sternberg cells.
The patient presents with painless enlargement of peripheral lymph nodes,extranodal involvement is extremely rare.
Systemic symptoms e.g. low-grade fever and weight loss,and intercurrent infection may be present & pruritus.
The aetiology of these tumors is related to infection with Epstein-Barr virus (EBV) (this virus is also related to the development of nasopharyngeal carcinoma and infectious mononucleosis).
The diagnosis is made by lymph node biopsy.
The extent of involvement by HL is defined by the Ann Arbor staging system.
Macroscopic Pathology
The affected lymph nodes are usually discrete and rubbery,but may be matted together.
They have a grey-pink cut surface, often with areas of necrosis. There may be dense bands of fibrous tissue around and within the node
Microscopically
the presence of a small population of large neoplastic cells, theHodgkin/Reed–Sternberg cell, and second a large population
of non-neoplastic inflammatory cells.
The WHO classification of HL
1-Classical type:
1. Nodular sclerosis
2. Mixed cellularity
3. Lymphocyte-rich
4. Lymphocyte depletion
2-Nodular Lymphocyte predominance HL
Nodular lymphocyte predominant does not show RS cells.
Diagnosis and histological classification
The diagnosis is made by histological examination of an excised lymph node. The distinctive multinucleate polyploid RS cell is central to the diagnosis of the four classic types and mononuclear Hodgkin cells are also part of the malignant clone.
These cells stain with CD30 and CD15.
LEC:7
Malignant lymphoma
Nodular Sclerosis Type.
This is the most common form of HL(40%)
Deposition of collagen in bands that divide involved lymph nodes into circumscribed nodules
lacunar variant Reed-Sternberg cells
Frequent mediastinal involvement;
equal occurrence in males and females (F = M), most patients young adults
Mixed cellularity 30%
More than 50% present as stage III or IV disease;M greater than F
peaking in young adults and again in adults older than 55Y
Frequent mononuclear and diagnostic RS cells; background infiltrate rich in lymphocytes, eosinophils, macrophages, plasma cells.
Lymphocyte rich 15%
Uncommon; M greater than F; tends to be seen in older adultsFrequent mononuclear and diagnostic RS cells; background infiltrate rich in lymphocytes
Lymphocyte depletion 15%
more common in older males, HIV-infected individuals, and in developing countries; often presents with advanced disease
It has bad prognosis.
Non-Hodgkin`s lymphoma
General characters:
1.Monoclonal proliferation of single transformed cell arrested at a certain stage during transformation (or differentiation) with variable behaviour.
Lymphoid stem cells –Pre B cells—mature (peripheral) B cells—plasma cells.
Lymphoid stem cell—pre T—mature T (thymocyte).
2. Can be nodal (2/3rd) or extranodal (1/3rd).
3.More than 80% are of B cell type.
4- They are heterogeneous group of tumors with wide range of clinical behavior (from low to high grade)
5 - Low grades , grow slowly, are often disseminated . High grade are usually localised , grow rapidly & respond to chemotherapy
Non-Hodgkin Lymphoma
The diagnosis of these tumors depends on histological, immunohistochemical and molecular genetic techniques.
The aetiology of NHL is unknown, a number of viruses may be associated with some types of NHL, for example EB virus is associated with Burkitt lymphoma, Hepatitis C virus and primary splenic lymphoma.
NHL is classified into B-cell lymphomas and T-cell lymphomas.
The WHO classification of Lymphoma is based on
H&E stain,
Immunohistochemical stain CD markers
Genetic informations
Clinical features of the patient
classify lymphomas into the following groups:
NHL-Examples
Tumors of Pre B and Pre T cells (precursor cells)
(Lymphoblastic lymphomas):
Affect children, of high grade of malignancy.
Cure is possible with aggressive chemotherapy.
Lymphoma/leukaemia picture.
Involvement of extranodal sites (testis, CNS ,liver).
85% of B cell
T = Thymic mass.
NHL- Peripheral B cell lymphomas
CLL (lymphoma/leukaemia):
Diffuse lymphoma of small lymphocytes.
L increased (absolute count in peripheral blood).
Most common lymphoma in adults. GLA, hepato splenomegaly with BM involvement.
Low grade malignancy but may progress to Richter`s syndrome (high grade)
NHL-Peripheral B cell lymphoma
Burkitt`s Lymphoma (high grade) two types :
1. Endemic due to EBV infection.
2. Non endemic.
Both occur in children & young adults ,mainly in extranodal sites.
Both are associated with Translocation 8: 14 and activation of c-myc(transcrptional proto oncogen).
Organs of involvement : GIT, ovary, mandible .
Microscop.diffuse lymphoblastic infiltration with starry sky appearance.
NHL-Peripheral B cell lymphoma
Follicular lymphoma :Most common type in western countries.
Very uncommon in Iraq.
Always nodal, of low grade of malignancy.
Associated with translocation 14: 18(apoptosis regulating gene).
Immunophenotyping study CD10 positive
Thymus
Composed of lymphocytes & specialized epithelial cells (Hassall corpuscles).Functions: development of T cells
Absence leads to deficiency of T cell mediated immunity.
Tumors :lymphomas, germ cell tumors, neuroendocrine tumors (may be functional).
Thymomas from epithelial components:
80% are benign ,10% low grade of malignancy ,10% show metastasis.
May be associated with mysthenia gravis, red cell aplasia & autoimmune conditions.